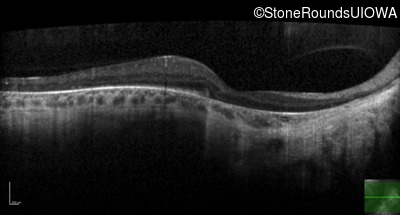
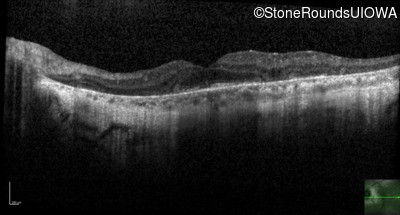
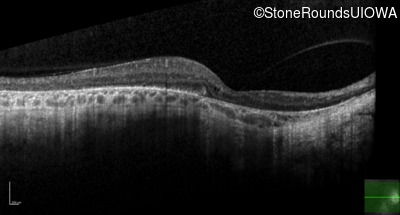
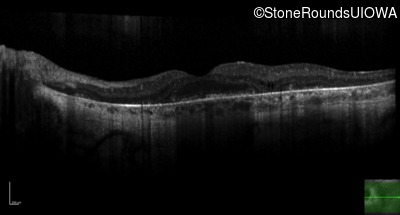
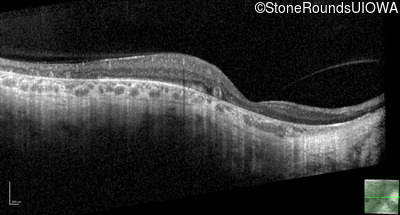
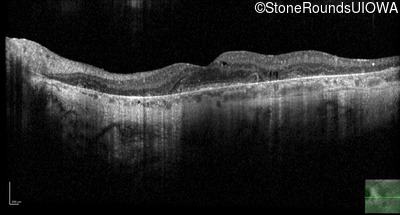
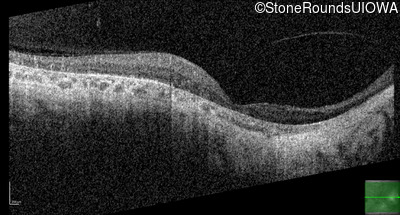
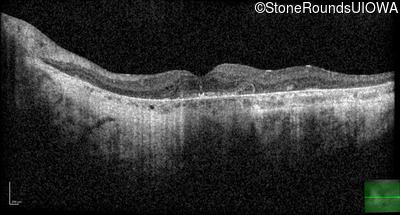
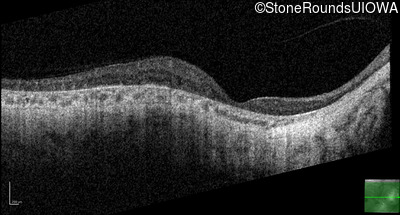
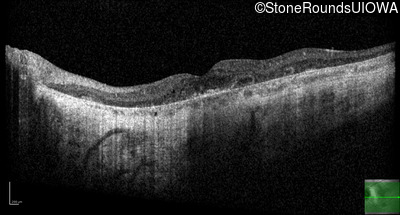

Case
SR1715
Student Mode
XL Choroideremia (IIIA1a)
Male
Male
Hidden
SR1715
Student Mode
XL Choroideremia (IIIA1a)
Male
Male
Highlighted Images
| Age at visit: 46 years | OD | OS |
|---|---|
History
This 46 year old man first had difficulty driving at night in his mid-thirties. Clinically focused genetic testing for Choroideremia was negative.
| Age at visit: 46 years |
| OD | OS | ||
|---|---|---|---|
| OD | OS | ||
|---|---|---|---|
| OD | OS | ||
|---|---|---|---|
| OD | OS | ||
|---|---|---|---|
| Age at visit: 47 years |
| OD | OS | ||
|---|---|---|---|
| OD | OS | ||
|---|---|---|---|
| Age at visit: 49 years |
| OD | OS | ||
|---|---|---|---|
| OD | OS | ||
|---|---|---|---|
| Age at visit: 51 years |
| OD | OS | ||
|---|---|---|---|
| OD | OS | ||
|---|---|---|---|
| OD | OS | ||
|---|---|---|---|
Diagnosis & molecular findings
| Disease | Gene | Allele 1 variant(s) | Allele 2 variant(s) | Inheritance mode |
|---|---|---|---|---|
| XL Choroideremia | CHM | Insertion of 212.3kb of Chr. 3 in intron 2 (IVS2+15,016 ins 212.3kb) | XL |
Disease:
Gene:
Allele 1:
Insertion of 212.3kb of Chr. 3 in intron 2 (IVS2+15,016 ins 212.3kb)
Allele 2:
Inheritance:
XL